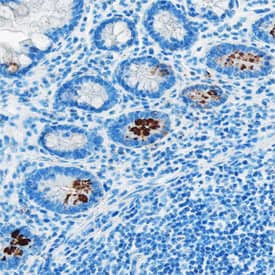
Acylated Ghrelin Antibody in Immunohistochemistry (Paraffin) (IHC (P))

Search
Invitrogen
Acylated Ghrelin Monoclonal Antibody (891240)
{{$productOrderCtrl.translations['antibody.pdp.commerceCard.promotion.promotions']}}
{{$productOrderCtrl.translations['antibody.pdp.commerceCard.promotion.viewpromo']}}
{{$productOrderCtrl.translations['antibody.pdp.commerceCard.promotion.promocode']}}: {{promo.promoCode}} {{promo.promoTitle}} {{promo.promoDescription}}. {{$productOrderCtrl.translations['antibody.pdp.commerceCard.promotion.learnmore']}}

Please note: We are reviewing Western blot images included in the antibody testing data in our catalog, including those provided by third parties. Unless expressly labeled or annotated as “raw-unedited”, Western blot images included in the antibody testing data in our catalog may have been edited, optimized or otherwise adjusted for presentation.
产品信息
MA5-61918
种属反应
宿主/亚型
分类
类型
克隆号
抗原
偶联物
形式
浓度
规格
纯化类型
保存液
内含物
保存条件
运输条件
RRID
产品详细信息
Reconstitute at 0.5 mg/mL in sterile PBS.
靶标信息
Acylated ghrelin is a hormone primarily produced by the stomach and released into the bloodstream. It plays a significant role in regulating appetite and energy balance. Functionally, acylated ghrelin acts as an orexigenic hormone, meaning it stimulates appetite and promotes food intake. It interacts with specific receptors in the brain, particularly the growth hormone secretagogue receptor 1a (GHSR1a), to increase hunger signals and enhance food-seeking behaviors. Acylated ghrelin also influences energy homeostasis by increasing fat storage and reducing energy expenditure. Structurally, acylated ghrelin is a peptide hormone consisting of 28 amino acids. It undergoes a post-translational modification process called acylation, where a fatty acid (usually octanoic acid) is attached to the third amino acid residue (serine) in the peptide chain. This acylation is crucial for the hormone's biological activity and stability. Localization-wise, acylated ghrelin is primarily produced by the X/A-like cells in the gastric mucosa. After secretion into the bloodstream, it acts on various target tissues, including the hypothalamus, pituitary gland, and adipose tissue. The hypothalamus is particularly important for regulating appetite and energy balance, as it receives and integrates signals from acylated ghrelin.
仅用于科研。不用于诊断过程。未经明确授权不得转售。
篇参考文献 (0)
生物信息学
蛋白别名: A-GHRL